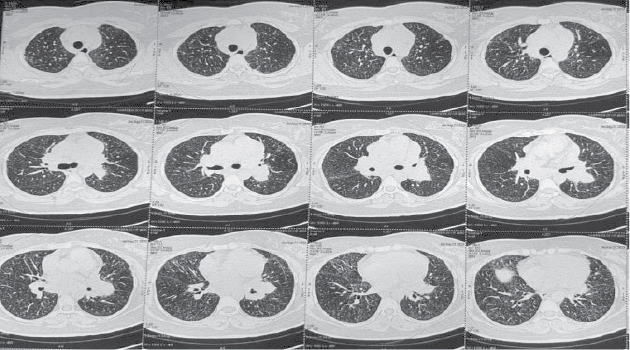

Published in IJCP
July 2025
Case Report
Renal Sarcoidosis: A Rare Masquerader of Asthma
July 12, 2025 | Siddharth Raj Yadav, Sourabh Sharma, Subankar Chakraborty, Nitin Goel, Himanshu Verma
Pulmonary Medicine
Abstract
Background: Sarcoidosis is a systemic granulomatous disease with a predilection for pulmonary involvement, while renal sarcoidosis remains rare and under-recognized. The protean manifestations, particularly in the kidneys, often lead to misdiagnosis
and delayed treatment. Case presentation: We report the case of a 38-year-old female with persistent respiratory symptoms initially misdiagnosed and treated as bronchial asthma for over a year. Further evaluation revealed chronic kidney disease
with elevated serum creatinine and imaging suggestive of mediastinal lymphadenopathy. Endobronchial ultrasound-guided lymph node biopsy demonstrated noncaseating granulomas, and a renal biopsy confirmed granulomatous interstitial nephritis. A diagnosis
of multisystem sarcoidosis with renal and pulmonary involvement was made. The patient responded favorably to corticosteroid therapy, with significant improvement in both renal function and pulmonary parameters over a 3-month follow-up period. Conclusion: This case highlights the importance of maintaining a high index of suspicion for sarcoidosis in young patients with unexplained respiratory symptoms and renal dysfunction. Early renal biopsy and histological confirmation are crucial to prevent irreversible
organ damage. Multidisciplinary collaboration is essential for accurate diagnosis and optimal management.
Keywords: Asthma, chronic kidney disease, granuloma, granulomatous interstitial nephritis, lymphadenopathy, pulmonary function test, sarcoidosis
Sarcoidosis is a multisystem disease caused by noncaseating granulomas in multiple organs1. The causes of sarcoidosis are still unknown; an interaction between several genetic variants and environmental exposures is thought to trigger
and sustain granulomatous inflammation and clinical disease. The annual incidence of sarcoidosis varies between 1 and 15 per 1,00,000 depending on the region. The rates are lowest in Eastern Asian countries (0.5-1 per 1,00,000)2,3, higher
in North America and Australia4, and highest in Northern European (Scandinavian) countries5. Although sarcoidosis patients predominantly present with pulmonary symptoms, there may be features of other system involvement like
lymph nodes, hepatic, cardiac, and central nervous system. Renal involvement in sarcoidosis can occur but rarely. Renal manifestations of sarcoidosis can be vague and can vary according to the underlying pathological mechanism. The diagnosis considering
its rarity can be very challenging at times. It has a wide spectrum of presentation including abnormal calcium metabolism, nephrolithiasis, nephrocalcinosis, and acute tubulointerstitial nephritis with or without granulomas
6,7.
CASE
SUMMARY
A 38-year-old female presented to the outpatient department with shortness of breath for 1.5 years and a cough lasting 1 year. Her shortness of breath was intermittent, worsening in winter, and accompanied by wheezing. She experienced a predominant dry
cough, particularly in winter, triggered by dust and smoke. Additionally, she had a brief exposure to pigeons for 3 to 4 months a year ago. Initially diagnosed with asthma, she was treated with inhalers but experienced only partial symptom relief.
Over the last 4 months, she reported a loss of appetite and a weight loss of 4 kg. She was referred to our center for management of uncontrolled asthma. Upon further probing, there was no history of allergies or family history of respiratory
illness. Notably, she had pulmonary tuberculosis (on clinicoradiological basis) 21 years prior, treated with antitubercular drugs for 6 months. She also reported unexplained fatigue for the past 5 months. Initial blood tests revealed a normal hemogram
(Hemoglobin [Hb] 13.2 g/dL, total leukocyte count [TLC] 7.07 K, absolute eosinophil count [AEC] 337 cells) and normal liver function tests; but kidney function tests were abnormal (urea 60.9 mg/dL, creatinine 2.43 mg/dL).
For deranged kidney function tests (KFT), urine routine microscopy was done, which was normal (pH 6.0, protein, RBC, sugar - nil, epithelial cells - 2-4 cells/HPF, pus cells - 1-2 cells/HPF). Ultrasound KUB (kidney, ureter, bladder) showed normal sized
kidneys with mildly increased bilateral cortical echogenicity. Contrast-enhanced computed tomography (CECT) thorax was not feasible as creatinine was high, so noncontrast computed tomography (NCCT) thorax was done which showed multiple enlarged
mediastinal and hilar lymph nodes with minimal thickening of interlobular and intralobular septae in both lungs with areas of ground-glass opacities and diffuse centrilobular nodules(Figs. 1 and 2). Inter stitial lung disease work up sent,
which showed rheumatoid arthritis and antinuclear antibodies (hep2), C-reactive protein, anti-cyclic citrullinated peptide - negative, serum angiotensin-converting enzyme (ACE) 90 (cut-off <68). C-antineutrophil cytoplasmic antibodies (ANCA),
p-ANCA was also negative. Pulmonary function tests (PFT) showed restrictive disorder (Table 1) and 6-minute walk distance of 420 meter without significant desaturation.
Figure
1. NCCT Thorax - Centrilobular nodules and septal thickening in parenchymal window.

Figure
2. NCCT Thorax - Mediastinal lymphadenopathy.
|
Table 1. Complete Pulmonary Function Test
|
|
Parameters
|
Pred
|
LLN
|
Best
|
% Pred
|
Z score
|
|
FVC (L)
|
2.28
|
1.76
|
1.37
|
60
|
-2.90
|
|
FEV1 (L)
|
1.80
|
1.32
|
1.08
|
60
|
-2.49
|
|
FEV1/FVC (%)
|
78.7
|
70.3
|
79.2
|
101
|
0.09
|
|
Parameters
|
Pred
|
LLN
|
Result
|
% Pred
|
Z score
|
|
VC (L)
|
2.28
|
1.76
|
1.21
|
53
|
-3.40
|
|
FRC mb (L)
|
2.10
|
1.35
|
1.03
|
49
|
-2.33
|
|
RV mb (L)
|
1.13
|
0.60
|
0.49
|
43
|
-2.00
|
|
TLC mb (L)
|
3.48
|
2.57
|
1.70
|
49
|
-3.22
|
|
RV/TLC mb (%)
|
31.9
|
22.3
|
28.6
|
90
|
-0.56
|
Pred = Predicted; LLN = Lower limit of normal; FVC = Forced vital capacity; FEV1 = Forced expiratory volume in 1 second; VC = Vital capacity; FRC = Functional residual capacity; RV = Residual volume; TLC = Total lung capacity.
Endobronchial ultrasound (EBUS) was done which showed enlarged station 4R, 4L, 7, 10R and 10L. EBUS-TBNA (transbronchial needle aspiration) done from all lymph node stations sequentially. EBUS-FNA (fine-needle aspiration) cytology showed well-formed epithelioid
granuloma; acid-fast bacilli (AFB) stain was negative. EBUS core biopsy sample also showed ill-defined noncaseating granuloma; AFB stain was negative, and Mycobacterium tuberculosis was not detected by GeneXpert. Patient was also referred
to Nephrologist for opinion due to deranged KFT. The patient underwent renal biopsy, which showed features of granulomatous interstitial nephritis. Focal glomerulosclerosis and mild interstitial fibrosis with tubular atrophy (15%) seen along with
evidence of tubular injury (Figs. 3 and 4). So, a final diagnosis of sarcoidosis with both lung and renal involvement was made.

Figure
3. EBUS-FNA: Well-formed noncaseating epitheloid granuloma (white arrow).

Figure
4. Renal biopsy: Granulomatous interstitial nephritis (tubular injury- arrow, ill-defined granuloma- star).
|
Table 2. Follow-up Spirometry after 3 Months Treatment
|
|
Parameters
|
Pre
|
Best
|
% Pred
|
Post
|
% Pred
|
|
FVC (L)
|
2.33
|
1.71
|
73
|
1.79
|
77
|
|
FEV1 (L)
|
2.00
|
1.57
|
79
|
1.50
|
75
|
|
FEV1/FVC (%)
|
|
92%
|
|
84%
|
|
The patient was started on oral prednisolone at a dose of 0.5 mg/kg body weight, and gradually tapered down. After 1 month of treatment patient was symptomatically improved. Blood parameters showed Hb 12 mg/dL, TLC 11K, with marked improvement of KFT,
urea 47, and creatinine 1.14. At present patient completed 3 months of oral steroid. Repeat PFT showed significant improvement in forced expiratory volume in 1 second (FEV1) (Table 2).
DISCUSSION
Historically, renal involvement is considered infrequent in sarcoidosis with an incidence of 0.7% and is seldom the presenting feature of the illness. However, recent evidence suggests that renal involvement in sarcoidosis might be underestimated.
A retrospective study reports that 32% of 78 patients with sarcoidosis were diagnosed with renal failure8. Dysregulated calcium metabolism is commonly seen in sarcoidosis, and it often manifests as nephrolithiasis and nephrocalcinosis secondary
to hypercalcemia, which rarely leads to clinically significant kidney disease. The histopathological hallmark of renal sarcoidosis is granulomatous interstitial nephritis, which may be found in 30% to 78.7% of renal sarcoidosis cases
9,10.But in some studies, nongranulomatous tubulointerstitial nephritis is the most common histological entity (44%), followed by granulomatous interstitial nephritis (30%), IgA-GN (26%), and nephrocalcinosis (11%)
11. In our case, it was granulomatous interstitial nephritis. Some of the rare manifestations include amyloid A (AA) amyloidosis, urinary tract obstruction with renal masses, and glomerular diseases such as proliferative
or crescentic glomerulonephritis, and focal segmental glomerulosclerosis12-14.
In our case, high serum creatinine, an elevated ACE and histologically proven non-necrotizing granuloma from EBUS-guided FNA and biopsy, granulomatous acute interstitial nephritis on renal biopsy made the diagnosis of sarcoidosis likely. Nevertheless,
other etiologies of granulomatous interstitial nephritis had to be excluded. In addition to sarcoidosis, the most frequent causes are drugs, infections (such as tuberculosis or syphilis), Wegener’s disease and tubulointerstitial nephritis and uveitis15-17.Our
patient denied any prescribed or over-the-counter medication. Tuberculosis, syphilis, and granulomatosis with polyangiitis (Wegener’s disease) was unlikely with the patients’ clinical presentation and laboratory parameters.
This case is particularly interesting for its atypical presentation as the patient was initially misdiagnosed and treated as bronchial asthma for more than 1 year due to similar clinical presentation. Although acute renal injury (which is rare in the
context of acute granulomatous interstitial nephritis) and mediastinal lymphadenopathy stands out to be the clinical differentiator. Two studies showed renal function improvement after oral corticosteroids treatment, as observed in our patient11,18.
There was also significant improvement in pulmonary function as evidenced by repeat spirometry after 3 months.
CONCLUSION
Renal sarcoidosis, though rare, poses a significant diagnostic challenge due to its nonspecific presentation and low prevalence. This case underscores the need to consider sarcoidosis in the differential diagnosis of young patients presenting with unexplained
renal dysfunction, especially when accompanied by systemic symptoms such as weight loss, fatigue, or persistent respiratory complaints misattributed to asthma. Early histopathological diagnosis through renal and lymph node biopsy, along with
the exclusion of other granulomatous diseases, is imperative. Prompt initiation of corticosteroid therapy can lead to significant clinical and biochemical improvement, as demonstrated in this case. Raising awareness about atypical presentations of
sarcoidosis can help avoid delays in diagnosis and reduce long-term morbidity.
REFERENCES
- Grunewald J, Grutters JC, Arkema EV, Saketkoo LA, Moller DR, Müller-Quernheim J. Sarcoidosis. Nat Rev Dis Primers. 2019;5(1):45.
- Yoon HY, Kim HM, Kim YJ, Song JW. Prevalence and incidence of sarcoidosis in Korea: a nationwide population-based study. Respir Res. 2018;19(1):158.
- Pietinalho A, Hiraga Y, Hosoda Y, Löfroos AB, Yamaguchi M, Selroos O. The frequency of sarcoidosis in Finland and Hokkaido, Japan. A comparative epidemiological study. Sarcoidosis. 1995;12(1):61-7.
- Baughman RP, Field S, Costabel U, Crystal RG, Culver DA, Drent M, et al. Sarcoidosis in America: analysis based on health care use. Ann Am Thorac Soc. 2016;13(8):1244-52.
- Arkema EV, Grunewald J, Kullberg S, Eklund A, Askling J. Sarcoidosis incidence and prevalence: a nationwide register-based assessment in Sweden. Eur Respir J. 2016;48(6):1690-9.
- Baughman RP, Teirstein AS, Judson MA, Rossman MD, Yeager H Jr, Bresnitz EA, et al; Case Control Etiologic Study of Sarcoidosis (ACCESS) research group. Clinical characteristics of patients in a case control study of sarcoidosis. Am J Respir Crit Care
Med. 2001;164(10 Pt 1):1885-9.
- Menezes M, Patarata E. Renal sarcoidosis: a rare case. BMJ Case Rep. 2018;11(1):e227023.
- Gorsane I, Zammouri A, Hajji M, Sallemi N, Aoudia R, Barbouch S, et al. Atteinte rénale au cours de la sarcoïdose: facteurs pronostiques et prédictifs [Renal involvement in sarcoidosis: prognostic and predictive factors]. Nephrol Ther. 2022;18(1):52-8.
French.
- Mahévas M, Lescure FX, Boffa JJ, Delastour V, Belenfant X, Chapelon C, et al. Renal sarcoidosis: clinical, laboratory, and histologic presentation and outcome in 47 patients. Medicine (Baltimore). 2009;88(2):98-106.
- Zammouri A, Barbouch S, Najjar M, Aoudia R, Jaziri F, Kaaroud H, et al. Tubulointerstitial nephritis due to sarcoidosis: clinical, laboratory, and histological features and outcome in a cohort of 24 patients. Saudi J Kidney Dis Transpl. 2019;30(6):1276-84.
- Löffler C, Löffler U, Tuleweit A, Waldherr R, Uppenkamp M, Bergner R. Renal sarcoidosis: epidemiological and follow-up data in a cohort of 27 patients. Sarcoidosis Vasc Diffuse Lung Dis. 2015;31(4):306-15.
- Casella FJ, Allon M. The kidney in sarcoidosis. J Am Soc Nephrol. 1993;3(9):1555-62.
- Dahl K, Canetta PA, D’Agati VD, Radhakrishnan J. A 56-year-old woman with sarcoidosis and acute renal failure. Kidney Int. 2008;74(6):817-21.
- Goldszer RC, Galvanek EG, Lazarus JM. Glomerulonephritis in a patient with sarcoidosis. Report of a case and review of the literature. Arch Pathol Lab Med. 1981;105(9):478-81.
- Javaud N, Belenfant X, Stirnemann J, Laederich J, Ziol M, Callard P, et al. Renal granulomatoses: a retrospective study of 40 cases and review of the literature. Medicine (Baltimore). 2007;86(3):170-80.
- Joss N, Morris S, Young B, Geddes C. Granulomatous interstitial nephritis. Clin J Am Soc Nephrol. 2007;2(2):222-30.
- Shah S, Carter-Monroe N, Atta MG. Granulomatous interstitial nephritis. Clin Kidney J. 2015;8(5):516-23.
- Hilderson I, Van Laecke S, Wauters A, Donck J. Treatment of renal sarcoidosis: is there a guideline? Overview of the different treatment options. Nephrol Dial Transplant. 2014;29(10):1841-7.
|